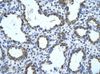

G protein alpha S (GNAS) Rabbit Polyclonal Antibody
Other products for "GNAS"
Specifications
| Product Data | |
| Applications | IHC, WB |
| Recommended Dilution | WB, IHC |
| Reactivities | Human, Mouse |
| Host | Rabbit |
| Isotype | IgG |
| Clonality | Polyclonal |
| Immunogen | The immunogen for anti-GNAS antibody: synthetic peptide directed towards the N terminal of human GNAS. Synthetic peptide located within the following region: SGKSTIVKQMRILHVNGFNGDSEKATKVQDIKNNLKEAIETIVAAMSNLV |
| Formulation | Liquid. Purified antibody supplied in 1x PBS buffer with 0.09% (w/v) sodium azide and 2% sucrose. Note that this product is shipped as lyophilized powder to China customers. |
| Conjugation | Unconjugated |
| Storage | Store at -20°C as received. |
| Stability | Stable for 12 months from date of receipt. |
| Predicted Protein Size | 42 kDa |
| Gene Name | GNAS complex locus |
| Database Link | |
| Background | Mutations in GNAS gene result in pseudohypoparathyroidism type 1a, pseudohypoparathyroidism type 1b, Albright hereditary osteodystrophy, pseudopseudohypoparathyroidism, McCune-Albright syndrome, progressive osseus heteroplasia, polyostotic fibrous dysplasia of bone, and some pituitary tumors.This gene has a highly complex imprinted expression pattern. It encodes maternally, paternally, and biallelically expressed proteins which are derived from alternatively spliced transcripts with alternate 5' exons. Each of the upstream exons is within a differentially methylated region, commonly found in imprinted genes. However, the close proximity (14 kb) of two oppositely expressed promoter regions is unusual. In addition, one of the alternate 5' exons introduces a frameshift relative to the other transcripts, resulting in one isoform which is structurally unrelated to the others. An antisense transcript exists, and may regulate imprinting in this region. Mutations in this gene result in pseudohypoparathyroidism type 1a (PHP1a), which has an atypical autosomal dominant inheritance pattern requiring maternal transmission for full penetrance. There are RefSeqs representing four transcript variants of this gene. Other transcript variants including four additional exons have been described; however, their full length sequences have not been determined. |
| Synonyms | AHO; C20orf45; GNAS1; GPSA; GSA; GSP; NESP; PHP1A; PHP1B; PHP1C; POH; SgVI |
| Note | Immunogen sequence homology: Pig: 100%; Rat: 100%; Human: 100%; Mouse: 100%; Bovine: 93%; Rabbit: 93% |
| Reference Data | |
| Protein Families | Druggable Genome, Secreted Protein |
| Protein Pathways | Calcium signaling pathway, Dilated cardiomyopathy, Gap junction, GnRH signaling pathway, Long-term depression, Melanogenesis, Taste transduction, Vascular smooth muscle contraction, Vibrio cholerae infection |
Documents
| Product Manuals |
| FAQs |
{0} Product Review(s)
0 Product Review(s)
Submit review
Be the first one to submit a review
Product Citations
*Delivery time may vary from web posted schedule. Occasional delays may occur due to unforeseen
complexities in the preparation of your product. International customers may expect an additional 1-2 weeks
in shipping.






























































































































































































































































 Germany
Germany
 Japan
Japan
 United Kingdom
United Kingdom
 China
China